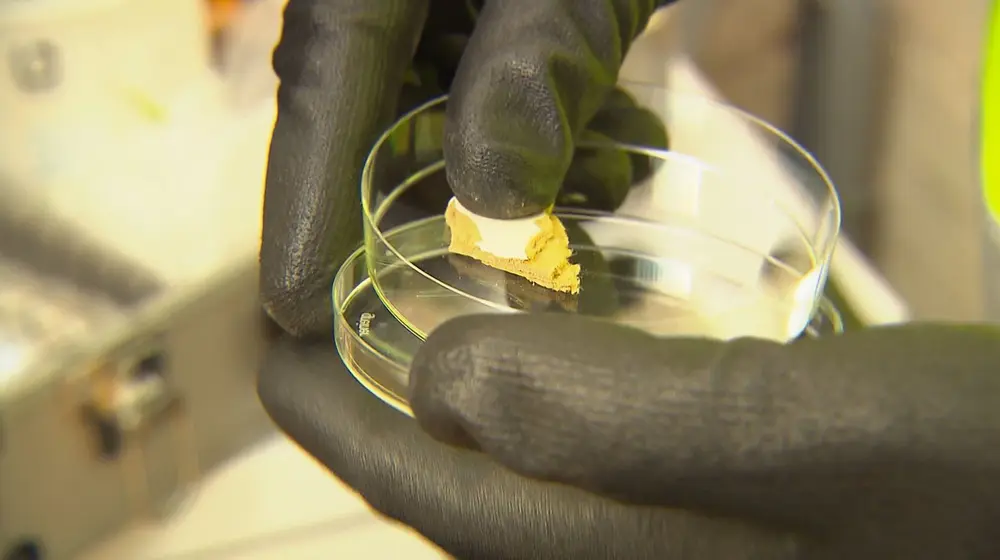
asbeststaal voor labo

Asbestattest: wat geldt per gewest?
Asbest zit nog in veel Belgische woningen, vooral gebouwd vóór 2001. Wie verkoopt of renoveert, krijgt te maken met regels, en die durven al eens te verschillen per gewest. In dit artikel lees je wat geldt in Vlaanderen, Brussel en Wallonië, wat een asbestattest of inventaris inhoudt en hoe je veilig en verstandig met asbest omgaat.
Asbestbeleid in Vlaanderen
Waarom een asbestbeleid?
Asbest werd vroeger massaal gebruikt in daken, buizen, isolatie, vloerbekleding en allerlei bouwmaterialen. Het probleem is niet alleen dat asbest ongezond is, maar ook dat materialen door veroudering en verwering geleidelijk meer risico kunnen vormen. Zelfs asbest dat “vast zit” (hechtgebonden) kan door slijtage vezels beginnen afgeven.
Daarom zet Vlaanderen sterk in op een asbestafbouwbeleid, met als doel om tegen 2040 “asbestveilig” te zijn. Concreet betekent dit dat asbest sneller opgespoord moet worden, eigenaars beter moeten weten waar de risico’s zich bevinden, en gevaarlijke toepassingen op een veilige manier verwijderd worden.
Wat is het asbestattest?
Een belangrijke stap in dat beleid is het asbestattest: een officieel document dat aangeeft waar in een gebouw asbest aanwezig is, in welke toestand het materiaal verkeert en welke risico’s dat oplevert. Het is een inventaris die per onderdeel aangeeft:
- welke materialen asbest bevatten,
- waar ze zich bevinden in het gebouw,
- de staat van het materiaal,
- een risico-inschatting,
- aanbevelingen voor beheer, opvolging of verwijdering.
In de praktijk ligt de prijs voor een asbestattest voor een doorsnee woning meestal tussen de € 500 en de € 700. De prijs hangt vooral af van het woningtype en de grootte, het aantal te inspecteren ruimtes/bijgebouwen, eventuele labo-kosten en de complexiteit/toegankelijkheid (zolder, kelder ...)

Wanneer is een asbestattest verplicht?
Bij verkoop van een woning
Een geldig asbestattest is op dit moment een verplicht document voor wie een woning wil verkopen met bouwjaar vóór 2001. Het attest moet beschikbaar zijn bij het sluiten van het compromis, of bij verkoop zonder compromis op het moment van overdracht.
Ook als je (nog) niet verkoopt, komt de verplichting eraan: tegen 2032 moet elke eigenaar van een woning gebouwd vóór 2001 over een asbestattest beschikken.
Wat met bijgebouwen?
Ook vrijstaande bijgebouwen (zoals een garage, tuinhuis of stal) kunnen onder de verplichting vallen, afhankelijk van de grootte en toegankelijkheid. OVAM (de Openbare Vlaamse Afvalstoffenmaatschappij) hanteert hierbij criteria zoals een minimale hoogte (minstens 1,75 m). Je hebt een attest nodig vanaf dat het bijgebouw een oppervlakte beslaat van 20 m² of groter. Als er meerdere kleine bijgebouwen zijn moet je de oppervlaktes optellen. Is de som groter of gelijk aan 20 m²? Dan is een asbestattest toch verplicht.
Wat met appartementen?
Voor appartementen geldt dat elk appartement een eigen asbestattest nodig heeft bij verkoop. Daarnaast bestaan er echter ook gemeenschappelijke delen (traphal, dak, gangen, technische lokalen…). Sinds 1 mei 2025 is het bij overdracht verplicht om ook een asbestattest voor de gemeenschappelijk gebruikte delen te hebben, indien van toepassing.
Tegen 2027 moeten VME’s (Verenigingen van Mede-Eigenaars) beschikken over een afzonderlijk asbestattest voor de gemeenschappelijke delen in mede-eigendom voor gebouwen van voor 2001.
En bij verhuur?
Bij verhuur is een asbestattest niet automatisch verplicht enkel omdat je verhuurt, maar wie over een attest beschikt moet wel een kopie bezorgen aan nieuwe huurders.
Tip
Sta je aan de vooravond van grote verbouwwerken? Dan is een asbestattest meestal niet verplicht, maar wel sterk aangewezen. Het helpt je om risico’s vooraf in kaart te brengen, veilig te plannen en onaangename (en vaak dure) verrassingen op de werf te vermijden.
Hoe wordt een asbestattest opgesteld?
Een asbestattest mag alleen opgesteld worden door een gecertificeerde asbestdeskundige, erkend binnen het OVAM-systeem. Die komt ter plaatse en voert een visuele inspectie uit van de toegankelijke ruimtes en constructies. Daarbij wordt gekeken naar:
- mogelijke asbesthoudende materialen (daken, platen, leidingen, vloerbekleding, isolatie …),
- de toestand van die materialen (intact, beschadigd, verweerd …),
- het risico bij normaal gebruik van de woning.
Wanneer er twijfel is, kan de deskundige stalen nemen voor labo-analyse.
OVAM (de Openbare Vlaamse Afvalstoffenmaatschappij) levert het asbestattest af via haar centrale databank, nadat de deskundige alle gegevens digitaal heeft ingevoerd
Tip
Je vraagt het attest best zo vroeg mogelijk aan. Reken op een drietal weken tussen het bezoek van de deskundige en aflevering van het attest. Dit is afhankelijk van de agenda van de deskundige en of er staalnames/labo-analyse nodig zijn.
Hoe lang is een asbestattest geldig?
Standaard blijft een asbestattest 10 jaar geldig, maar als er hoog-risico asbestmaterialen aanwezig zijn, daalt de geldigheidsduur naar 5 jaar. Werd er bij de inspectie geen asbest vastgesteld, dan kan het attest zelfs onbeperkt geldig zijn. Een kortere geldigheid betekent overigens niet automatisch dat je alles meteen moet verwijderen, wel dat de risico’s groter zijn en opvolging belangrijker wordt.
Ingrijpende werken en renovaties: de asbestinventaris
Ga je een woning afbreken of grondig renoveren? Weet dan dat bij dergelijke werken de lat soms hoger ligt. Zodra je een aannemer inschakelt of er afbraak- en renovatiewerken gepland zijn, spelen ook de federale veiligheidsregels mee die werknemers moeten beschermen tegen asbest. In dat geval is vaak een extra asbestinventaris nodig, afgestemd op de geplande werken en de zones die worden opengebroken.
Zo'n inventaris is dus vooral nodig wanneer je werken laat uitvoeren waarbij je constructies openbreekt en verborgen materialen blootlegt. Denk aan slopen, strippen, nieuwe sanitaire leidingen of elektriciteitsleidingen infrezen, muren uitbreken, vloeren uitbreken of dakstructuur aanpassen.
Bij kleinere of oppervlakkige ingrepen (zoals schilderen, een nieuwe keuken zonder kapwerk, of afwerkingen vernieuwen zonder breekwerken) volstaat een eventueel asbestattest vaak als basis, al blijft voorzichtigheid bij oudere materialen belangrijk.
Verwijderen en behandelen van asbest: regels en veiligheid
Asbest is vooral gevaarlijk wanneer er vezels kunnen vrijkomen, bijvoorbeeld door materialen te schuren, slijpen of boren, door platen te breken of te verwijderen, of wanneer het gaat om verouderde, losse isolatie of beschadigd asbesthoudend materiaal.
Wanneer mag je zelf asbest verwijderen?
Voor sommige hechtgebonden toepassingen (zoals bepaalde golfplaten) mag je onder voorwaarden zelf verwijderen, maar dit hangt af van de staat van het materiaal, de werkwijze, de hoeveelheid, de veiligheid (stofvorming vermijden) en lokale afval- en verpakkingsregels.
In veel gevallen (zeker bij hoger risico) is werken met een erkende asbestverwijderaar de veiligste keuze. Als het materiaal zacht, broos, beschadigd of stoffig is, moet je er sowieso zelf af blijven en eerst laten beoordelen door een professional.
Asbestbeleid in Brussel en Wallonië
Brussels Hoofdstedelijk Gewest
In het Brussels Hoofdstedelijk Gewest bestaat er voorlopig geen verplicht asbestattest bij verkoop, maar er zijn er wel regels voor de verwijdering. Wie asbest laat verwijderen of inkapselen, krijgt te maken met duidelijke verplichtingen rond milieu en veiligheid.
Regels bij verwijdering
Zo moet je meestal vooraf een vergunning aanvragen (behalve bij heel kleine ingrepen). Daarnaast moet je in veel gevallen ook een melding/aangifte doen bij de gemeente vóór de start van de werken en de opgelegde voorwaarden naleven. Bovendien gelden er strikte regels voor veilig werken (om vezelverspreiding te vermijden) én voor de correcte afvoer van asbest als werfafval.
Het is dus sterk aangeraden om bij renovatieplannen niet te gokken, maar eerst te laten nagaan of er asbest aanwezig is, zeker bij oudere woningen. Laat je dus begeleiden als je plannen hebt om te renoveren of te slopen.
Mag je zelf asbest verwijderen?
Voor de meeste werken waarbij asbest moet worden verwijderd, moet je een vergunning aanvragen. Dat betekent dat je als particulier bijna altijd beter een erkende specialist inschakelt.
Asbestbeleid in Wallonië
Ook in Wallonië bestaat er vandaag geen verplicht asbestattest bij verkoop, zoals Vlaanderen dat wel heeft ingevoerd. Er is ook geen algemene verplichting om asbest te verwijderen. Toch blijft een asbestinventaris slim bij renovatie.
Bij asbestverwijdering, sloop of werken die asbestafval kunnen veroorzaken, is in Wallonië in de meeste gevallen een milieuvergunning (autorisation environnementale) of aangifte nodig. De procedure hangt af van de “klasse” van de werf in de milieuregels.
- Klasse 3 is de lichtste categorie: je hebt dan geen vergunning nodig, maar je moet wel een voorafgaande aangifte indienen bij de gemeente.
- Klasse 2 is zwaarder: dan moet je een milieuvergunning aanvragen, of een permis unique als er ook een stedenbouwkundige vergunning nodig is.
Bij particuliere woningen gaat het vaak om werken met asbestcement. In dat geval vallen veel werven (bij een middelgrote schaal) onder klasse 3 met aangifte, maar afhankelijk van de hoeveelheid, het type asbest en de werfcontext kan ook klasse 2 (vergunning) of soms geen procedure (voor kleine ingrepen met een laag risico) van toepassing zijn.
Daarnaast wordt asbestafval in Wallonië beschouwd als gevaarlijk afval: het moet correct verpakt worden en correct afgevoerd/verwerkt volgens de Waalse afvalregels.
Mag je zelf asbest verwijderen?
In principe mag je als particulier bepaalde hechtgebonden asbesttoepassingen zelf verwijderen, op voorwaarde dat het materiaal in goede staat is en je het zonder breken of stofvorming kan demonteren. Bij beschadigd, broos of losgebonden asbest is zelf verwijderen sterk af te raden en wordt meestal gewerkt met gespecialiseerde firma’s.